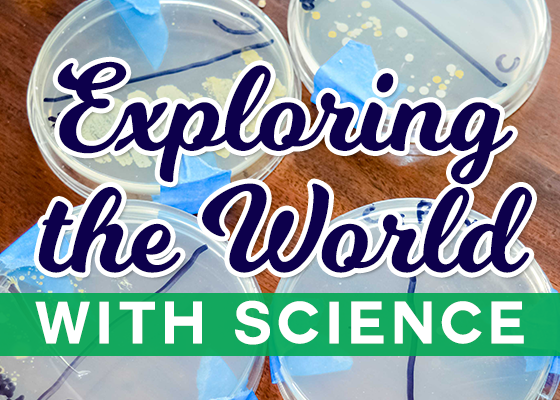

Exploring the World with Science

Children are naturally curious. They find wild delight in tiny ants crossing the sidewalk, they take pleasure in pulling out all the contents in your kitchen cabinets, and they love sticking their hands into gooey mud and rubbing it all over themselves and the dog. Children want to learn and explore the world around them – and it […]
Read Original Article: Exploring the World with Science »
Powered by WPeMatico